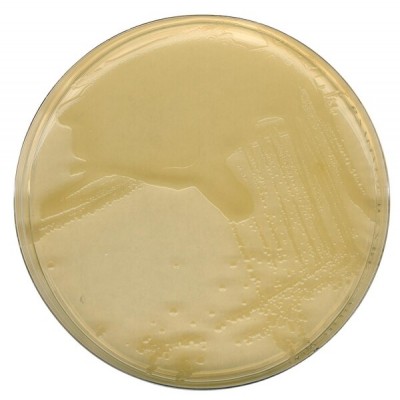
Los Angeles

LB AGAR (MILLER) MERCK - EMB 500G
Modelo: 1102830500
-
R$976,07
ou até 3x de R$325,36 sem juros
Economize 5% no PIX: R$927,27
ou 3.5% no boleto: R$941,91
Descrição
LB AGAR (MILLER) MERCK
REND. 37g/LITRO
EMBALAGEM 500G
Mode of Action
LB-Agar is based on the formulation of MILLER (1972) supporting growth of E. coli. Casein peptone and yeast extract supply essential growth factors, such as nitrogen, carbon, sulfur, minerals and vitamins.
Typical Composition (g/litre)
LB-Agar:
Yeast extract 5.0; peptone from casein 10.0; sodium chloride 10.0; agar-agar 12.0.
Preparation
Suspend 37 g LB-Agar in 1 litre of demin. water and autoclave for 15 min at 121 °C.
pH: 7.0 ± 0.2 at 25 °C.
The prepared agar is clear and yellowish-brown.
REND. 37g/LITRO
EMBALAGEM 500G
Mode of Action
LB-Agar is based on the formulation of MILLER (1972) supporting growth of E. coli. Casein peptone and yeast extract supply essential growth factors, such as nitrogen, carbon, sulfur, minerals and vitamins.
Typical Composition (g/litre)
LB-Agar:
Yeast extract 5.0; peptone from casein 10.0; sodium chloride 10.0; agar-agar 12.0.
Preparation
Suspend 37 g LB-Agar in 1 litre of demin. water and autoclave for 15 min at 121 °C.
pH: 7.0 ± 0.2 at 25 °C.
The prepared agar is clear and yellowish-brown.
Etiquetas: agar lb, lb agar, lb agar acc miller